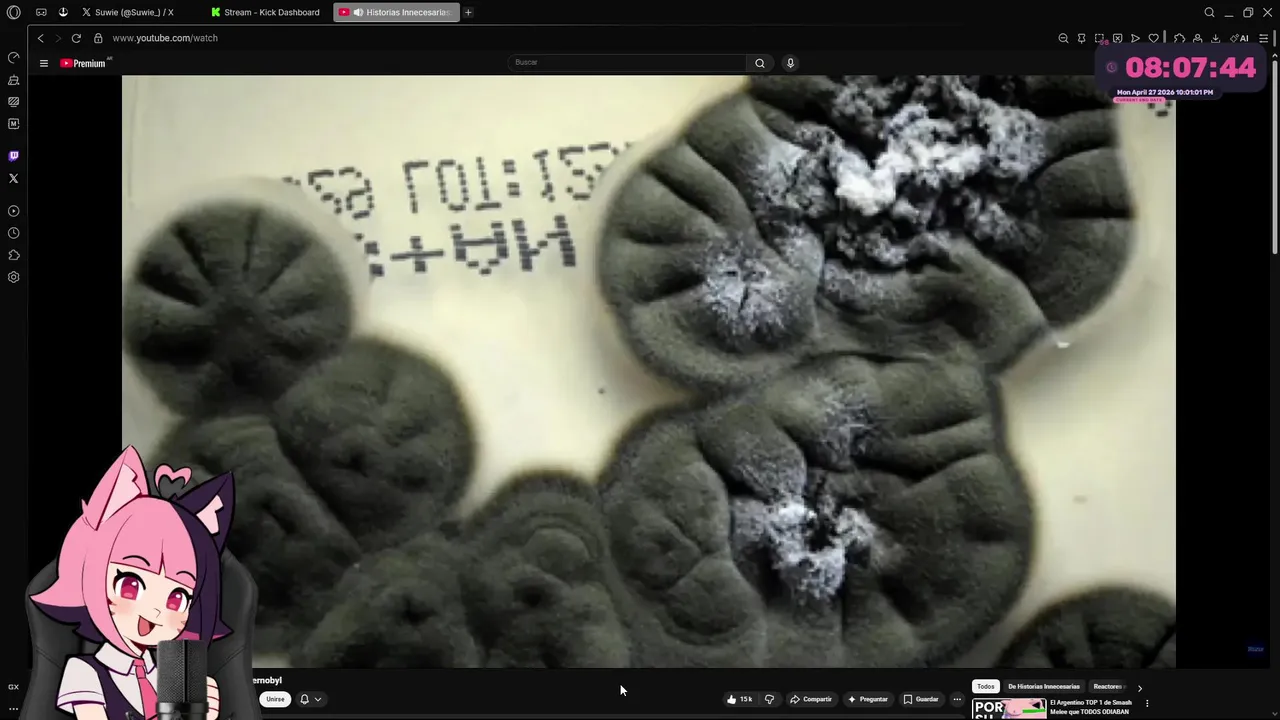

Language
-
1201
 茉茉(很白版)
on bigo.tv
茉茉(很白版)
on bigo.tv
Viewers: 89
Duration: 67 min. -
1202
 反白眼嘅XO
on 17.live
反白眼嘅XO
on 17.live
Viewers: 89
Duration: 71 min. -
1203
 AIイチナナベイビー
on 17.live
AIイチナナベイビー
on 17.live
Viewers: 89
Duration: 84 min. -
1204
 🎙️伊一(-46k)
on bigo.tv
🎙️伊一(-46k)
on bigo.tv
Viewers: 89
Duration: 240 min. -
1205
 𝓜𝓪𝔂𝓪𝓶𝓲
on bigo.tv
𝓜𝓪𝔂𝓪𝓶𝓲
on bigo.tv
Viewers: 89
Duration: 91 min. -
1206
 율스타⭐️
on bigo.tv
율스타⭐️
on bigo.tv
Viewers: 89
Duration: 163 min. -
1207
 Vanilla
on bigo.tv
Vanilla
on bigo.tv
Viewers: 89
Duration: 106 min. -
1208
류서하♥ on afreecatv.com
Viewers: 89
Duration: 57 min. -
1209
 紅顏女紙💕Betty💋
on 17.live
紅顏女紙💕Betty💋
on 17.live
Viewers: 89
Duration: 143 min. -
1210
 SnowmanSports
on twitch.tv
SnowmanSports
on twitch.tv
Viewers: 89
Duration: 26 min. -
1211
 MyDylsexia
on twitch.tv
MyDylsexia
on twitch.tv
Viewers: 88
Duration: 79 min. -
1212
 YourGalLaxi
on twitch.tv
YourGalLaxi
on twitch.tv
Viewers: 88
Duration: 137 min. -
1213
 pepelnayaa
on twitch.tv
pepelnayaa
on twitch.tv
Viewers: 88
Duration: 1 min. -
1214
 Broccoli
on twitch.tv
Broccoli
on twitch.tv
Viewers: 88
Duration: 39 min. -
1215
 Engis
on twitch.tv
Engis
on twitch.tv
Viewers: 88
Duration: 75 min. -
1216
 mickanplays
on twitch.tv
mickanplays
on twitch.tv
Viewers: 88
Duration: 2 min. -
1217
 rrosiana
on twitch.tv
rrosiana
on twitch.tv
Viewers: 88
Duration: 2 min. -
1218
 sammck
on kick.com
sammck
on kick.com
Viewers: 88
Duration: 12 min. -
1219
 Japan_ASMR
on twitch.tv
Japan_ASMR
on twitch.tv
Viewers: 88
Duration: 35 min. -
1220
 ᴸˣ璐璐(四月新主播)
on bigo.tv
ᴸˣ璐璐(四月新主播)
on bigo.tv
Viewers: 88
Duration: 91 min. -
1221
 仙🎤小糖罐负11K求救二档
on bigo.tv
仙🎤小糖罐负11K求救二档
on bigo.tv
Viewers: 88
Duration: 205 min. -
1222
 01(27号晚9点官p)
on bigo.tv
01(27号晚9点官p)
on bigo.tv
Viewers: 88
Duration: 176 min. -
1223
 ²¹⁴程嗯嗯-众筹103
on bigo.tv
²¹⁴程嗯嗯-众筹103
on bigo.tv
Viewers: 88
Duration: 66 min. -
1224
 嘉兒Kayi
on 17.live
嘉兒Kayi
on 17.live
Viewers: 88
Duration: 95 min. -
1225
 神ちゃん🐶kanchan🌺
on 17.live
神ちゃん🐶kanchan🌺
on 17.live
Viewers: 88
Duration: 36 min. -
1226
 Laila🍁
on bigo.tv
Laila🍁
on bigo.tv
Viewers: 88 -
1227
 27號22點官P🆘貓仔有九條命
on bigo.tv
27號22點官P🆘貓仔有九條命
on bigo.tv
Viewers: 88
Duration: 115 min. -
1228
 ,das Herz am ric
on bigo.tv
,das Herz am ric
on bigo.tv
Viewers: 88
Duration: 52 min. -
1229
 Stery_RJV
on twitch.tv
Stery_RJV
on twitch.tv
Viewers: 87 -
1230
 BUBENOW
on twitch.tv
BUBENOW
on twitch.tv
Viewers: 87
Duration: 19 min. -
1231
 SᵀA🐉ᴬᴹᴰᴺᴄᴜᴛɪᴇ
on bigo.tv
SᵀA🐉ᴬᴹᴰᴺᴄᴜᴛɪᴇ
on bigo.tv
Viewers: 87
Duration: 170 min. -
1232
 心星(四月新主播)
on bigo.tv
心星(四月新主播)
on bigo.tv
Viewers: 87
Duration: 75 min. -
1233
 Me Gusta 💧
on bigo.tv
Me Gusta 💧
on bigo.tv
Viewers: 87
Duration: 387 min. -
1234
 ゆらゆら🙈🤍🫧
on 17.live
ゆらゆら🙈🤍🫧
on 17.live
Viewers: 87
Duration: 99 min. -
1235
 忆白(-55k)
on bigo.tv
忆白(-55k)
on bigo.tv
Viewers: 87
Duration: 200 min. -
1236
 NaByy🖤
on bigo.tv
NaByy🖤
on bigo.tv
Viewers: 87
Duration: 214 min. -
1237
햄벅 on afreecatv.com
Viewers: 87
Duration: 169 min. -
1238
 shylostconfused
on twitch.tv
shylostconfused
on twitch.tv
Viewers: 86
Duration: 253 min. -
1239
 Timour_J
on twitch.tv
Timour_J
on twitch.tv
Viewers: 86
Duration: 325 min. -
1240
 altrumi
on twitch.tv
altrumi
on twitch.tv
Viewers: 86
Duration: 14 min. -
1241
 Vorterixok
on twitch.tv
Vorterixok
on twitch.tv
Viewers: 86
Duration: 601 min. -
1242
 Jr2swishyyy
on twitch.tv
Jr2swishyyy
on twitch.tv
Viewers: 86
Duration: 197 min. -
1243
 goodkidband
on twitch.tv
goodkidband
on twitch.tv
Viewers: 86
Duration: 29 min. -
1244
 ParnianBS
on twitch.tv
ParnianBS
on twitch.tv
Viewers: 86
Duration: 6 min. -
1245
 優姬トリ
on twitch.tv
優姬トリ
on twitch.tv
Viewers: 86
Duration: 88 min. -
1246
 أم العيال 💗🥀
on bigo.tv
أم العيال 💗🥀
on bigo.tv
Viewers: 86
Duration: -2 min. -
1247
 Anushay ❤❤
on bigo.tv
Anushay ❤❤
on bigo.tv
Viewers: 86
Duration: -5 min. -
1248
 соня
on bigo.tv
соня
on bigo.tv
Viewers: 86
Duration: -1 min. -
1249
 ЛЕХА
on bigo.tv
ЛЕХА
on bigo.tv
Viewers: 86
Duration: 35 min. -
1250
 ⚔️ سيف
on bigo.tv
⚔️ سيف
on bigo.tv
Viewers: 86
Duration: 2 min. -
1251
 Zalex509
on twitch.tv
Zalex509
on twitch.tv
Viewers: 86
Duration: 121 min. -
1252
 💜🎙E͙R͙I͙C͙A͙🧜♀️🫧💛
on 17.live
💜🎙E͙R͙I͙C͙A͙🧜♀️🫧💛
on 17.live
Viewers: 86
Duration: 54 min. -
1253
 la100oficial
on twitch.tv
la100oficial
on twitch.tv
Viewers: 85
Duration: 1861 min. -
1254
 upside_tools
on twitch.tv
upside_tools
on twitch.tv
Viewers: 85
Duration: 45 min. -
1255
 magic_mandofox
on twitch.tv
magic_mandofox
on twitch.tv
Viewers: 85
Duration: 159 min. -
1256
 BacwoodsTV
on twitch.tv
BacwoodsTV
on twitch.tv
Viewers: 85
Duration: 490 min. -
1257
Suwie
on kick.com
Suwie
on kick.com
Viewers: 85 -
1258
 沐晚🦋
on bigo.tv
沐晚🦋
on bigo.tv
Viewers: 85
Duration: 121 min. -
1259
 人机(4月新主播)
on bigo.tv
人机(4月新主播)
on bigo.tv
Viewers: 85
Duration: -4 min. -
1260
 🎙𝚁𝚎𝚒𝚝𝚘🌙🐾
on 17.live
🎙𝚁𝚎𝚒𝚝𝚘🌙🐾
on 17.live
Viewers: 85
Duration: 81 min. -
1261
 レイズ_VLiver
on 17.live
レイズ_VLiver
on 17.live
Viewers: 85
Duration: 174 min. -
1262
 poch173
on twitch.tv
poch173
on twitch.tv
Viewers: 85
Duration: 36 min. -
1263
2윤승 on afreecatv.com
Viewers: 85
Duration: 169 min. -
1264
 xFrostyWalker
on twitch.tv
xFrostyWalker
on twitch.tv
Viewers: 84
Duration: 7 min. -
1265
 pessinen
on twitch.tv
pessinen
on twitch.tv
Viewers: 84
Duration: 58 min. -
1266
 嶺上荏染
on twitch.tv
嶺上荏染
on twitch.tv
Viewers: 84
Duration: 58 min. -
1267
 Keola
on twitch.tv
Keola
on twitch.tv
Viewers: 84
Duration: 5 min. -
1268
 Besi523
on kick.com
Besi523
on kick.com
Viewers: 84 -
1269
 maciejmp
on kick.com
maciejmp
on kick.com
Viewers: 84
Duration: 12 min. -
1270
 J4OENT
on kick.com
J4OENT
on kick.com
Viewers: 84 -
1271
 幸运青瓷🎤等神等风等你
on bigo.tv
幸运青瓷🎤等神等风等你
on bigo.tv
Viewers: 84
Duration: 441 min. -
1272
 卡卡西^加油鸭
on bigo.tv
卡卡西^加油鸭
on bigo.tv
Viewers: 84
Duration: 192 min. -
1273
 Злой Колдун
on bigo.tv
Злой Колдун
on bigo.tv
Viewers: 84
Duration: -1 min. -
1274
 HarmfulOpinions
on twitch.tv
HarmfulOpinions
on twitch.tv
Viewers: 84
Duration: 53 min. -
1275
 breathcardin
on twitch.tv
breathcardin
on twitch.tv
Viewers: 83
Duration: 56 min. -
1276
 maumauChannel
on twitch.tv
maumauChannel
on twitch.tv
Viewers: 83
Duration: 43 min. -
1277
 MallieSprout
on twitch.tv
MallieSprout
on twitch.tv
Viewers: 83
Duration: 47 min. -
1278
 Develtycrash
on twitch.tv
Develtycrash
on twitch.tv
Viewers: 83
Duration: 68 min. -
1279
 RadioBianconera
on twitch.tv
RadioBianconera
on twitch.tv
Viewers: 83
Duration: 432 min. -
1280
 CuseSportsTalk
on twitch.tv
CuseSportsTalk
on twitch.tv
Viewers: 83
Duration: 52 min. -
1281
 ChaseCardsDE
on twitch.tv
ChaseCardsDE
on twitch.tv
Viewers: 83
Duration: 189 min. -
1282
 LeekBeats
on twitch.tv
LeekBeats
on twitch.tv
Viewers: 83
Duration: 1091 min. -
1283
 velhotel2
on twitch.tv
velhotel2
on twitch.tv
Viewers: 83
Duration: 214 min. -
1284
 campoaperto
on twitch.tv
campoaperto
on twitch.tv
Viewers: 83
Duration: 58 min. -
1285
 nicoleberenice
on kick.com
nicoleberenice
on kick.com
Viewers: 83 -
1286
 xDomciaaa
on kick.com
xDomciaaa
on kick.com
Viewers: 83 -
1287
 RKBEKCI
on kick.com
RKBEKCI
on kick.com
Viewers: 83 -
1288
 Adrianeowmen
on kick.com
Adrianeowmen
on kick.com
Viewers: 83 -
1289
 3adooli
on kick.com
3adooli
on kick.com
Viewers: 83 -
1290
 Vige
on kick.com
Vige
on kick.com
Viewers: 83 -
1291
 ⛰️গল্প🌿
on bigo.tv
⛰️গল্প🌿
on bigo.tv
Viewers: 83
Duration: 57 min. -
1292
 ララバイ🌟SASURAI☪️
on 17.live
ララバイ🌟SASURAI☪️
on 17.live
Viewers: 83
Duration: 5 min. -
1293
 🌼阳阳☀️
on bigo.tv
🌼阳阳☀️
on bigo.tv
Viewers: 83
Duration: 48 min. -
1294
 Hilda🐼
on bigo.tv
Hilda🐼
on bigo.tv
Viewers: 83
Duration: 92 min. -
1295
 あおい💎🐰
on bigo.tv
あおい💎🐰
on bigo.tv
Viewers: 83
Duration: -3 min. -
1296
 💘Vy Yêu
on bigo.tv
💘Vy Yêu
on bigo.tv
Viewers: 83
Duration: -1 min. -
1297
IgorGHK on vkvideo.ru
Viewers: 83
Duration: 155 min. -
1298
 reikaa_
on 17.live
reikaa_
on 17.live
Viewers: 83
Duration: 142 min. -
1299
 chrisklive
on twitch.tv
chrisklive
on twitch.tv
Viewers: 82
Duration: 98 min. -
1300
 新東明娛樂
on twitch.tv
新東明娛樂
on twitch.tv
Viewers: 82
Duration: 135 min.





















